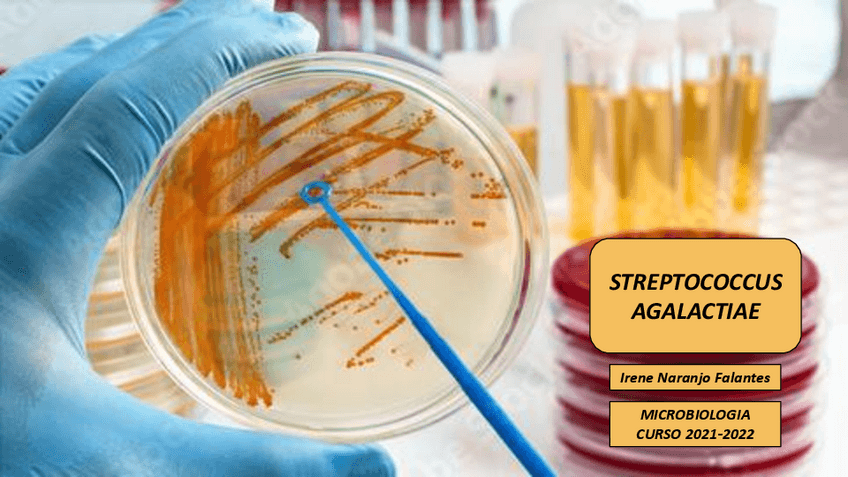

@irenenaranjoo
214 Publicaciones
6.14k Interacciones
15 Seguidores
0 Siguiendo
Lista de publicaciones de irenenaranjoo
apuntes
-
TABLAS RESUMEN MEDICAMENTOS
He publicado nuevos apuntes de 2º Farmacología: TABLAS RESUMEN MEDICAMENTOS
apuntes
-
TEMAS DIAPOSITIVA
He publicado nuevos apuntes de 2º Farmacología: TEMAS DIAPOSITIVA
He publicado nuevos ejercicios de 2º Ciencias Psicosociales Aplicadas: ACTIVIDAD-ROL-PLAYING.pdf
He publicado nuevos ejercicios de 2º Ciencias Psicosociales Aplicadas: REFLEXION-LIBRO-PERDER-LA-PIEL.pdf
He publicado nuevos apuntes de 1º Bases Teóricas y Metodológicas de los Cuidados de Enfermería: TEMARIO-EXAMENES-BASES-2021-2022.pdf
He publicado nuevos apuntes de 1º Organografía Microscópica Humana: IMAGENES-ORGANOGRAFIA-EXAMEN.pdf
apuntes
-
TRABAJO BACTERIA
He publicado nuevos apuntes de 1º Microbiología: TRABAJO BACTERIA
apuntes
-
CUADERNILLO DE ACTIVIDADES RESUELTO
He publicado nuevos apuntes de 1º Bioestadística, Metodología de la Investigación y Tecnología de la Información y Comunicación en Cuidados de Salud: CUADERNILLO DE ACTIVIDADES RESUELTO
apuntes
-
CASO CLINICO
He publicado nuevos apuntes de 1º Bases Teóricas y Metodológicas de los Cuidados de Enfermería: CASO CLINICO
apuntes
-
SEMINARIOS
He publicado nuevos apuntes de 1º Bioquímica y Fisiología Básica: SEMINARIOS
examenes
-
autoevaluaciones para examen
He publicado nuevos examenes de 1º Anatomía: autoevaluaciones para examen